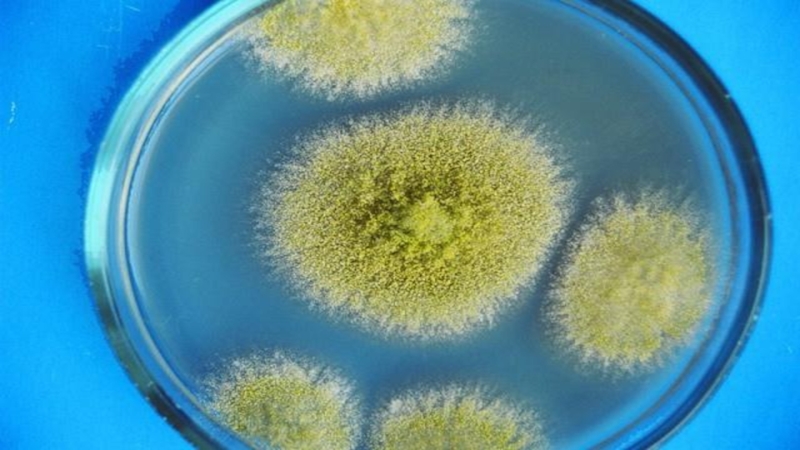

Слайд 21. История открытия грибов
Считается, что первое упоминание грибов в научной
литературе принадлежит Аристотелю. Ученик Аристотеля Теофраст, называемый «отцом ботаники», вероятно,
первым из античных мыслителей попытался систематизировать знания о грибах, известных в древности. Кроме того, в его трудах описаны болезни растений — мучнистая роса и ржавчина. Происхождение этих болезней античные учёные, конечно, ещё не могли связать с грибами, а объясняли влиянием избыточной влажности.
По большому счету, сведения и представления естествоиспытателей о микроскопических грибах, заметных невооруженным глазом только в виде различных налетов и плесеней, были еще более туманны.
В XVII в. микроскописты Р. Гук и М. Мальпиги наблюдали под микроскопом ржавчинные грибы и изображали их так точно, что по их рисункам и сейчас можно без особого труда определить описанные ими виды.
В 1833 г. в книге Франца Унгера "Сыпи у растений" развивалась подобная теория о паразитных микроскопических грибах. Шведский ботаник Э. М. Фрис (1794-1878), считается «отцом микологии». Он впервые причислил микроскопических возбудителей болезней растений к грибам, сделав при этом оговорку, что возникают они все-таки из клеток растений, на которых появляются.
Карл Линней в "Системе природы" в 1735 г. описал 95 видов грибов, однако, не сумев их классифицировать, определил выделенную им группу как хаос, в котором якобы невозможно найти никакой системы.

Слайд 3В первой половине XIX в. начались более широкие исследования грибов,
чему способствовало не только усовершенствование микроскопа, но и то, что
грибы оказались причиной болезней многих сельскохозяйственных растений. Учеными было описано множество макро- и микроскопических грибов, но, чтобы разобраться в их исключительном многообразии, необходимо было их классифицировать, как это сделал с цветковыми растениями Карл Линней.
Эту важнейшую в микологии работу сделали двое ученых — голландский врач Х.Г. Персон и шведский ботаник Э. М. Фрис. Двухтомный список грибов Х.Г. Персона, в котором он приводит кроме описаний видов вполне разработанную классификацию грибов, почти 30 лет был единственной полной сводкой, по которой можно было определить тот или иной вид или найти место среди близких видов для вновь открываемых. Описания Х.Г. Персона настолько точны, что названия многих видов грибов, установленные им, сохранены до настоящего времени
Э. Фриз написал фундаментальную книгу "Система микологии", которая выходила с 1821 по 1832 г. В ней было описано несколько тысяч видов грибов, в том числе микроскопических, распределенных по отдельным группам. Работы Э. Фриза создали фундамент для последующего развития самостоятельной науки о грибах — микологии.

Слайд 4«Мучнистая роса» и «Ржавчинные грибы»
Слайд 5Франц Унгер (1800-1870гг.) Элиас Магнус Фрис (1794 – 1878гг.)
Слайд 62. Общие сведения о грибах
Грибы относились к низшим растениям до
конца XX века. В 1970 году они были окончательно выделены
в отдельное царство Грибы, т.к. имеют ряд признаков, отличающих их от растений и сближающих с животными.
Общая характеристика
Царство грибы — это одноклеточные и многоклеточные организмы. В настоящее время систематики насчитали более 100 тыс. видов грибов.
Грибы — гетеротрофные организмы, не имеющие хлорофилла. Они занимают промежуточное положение между животными и растениями, так как характеризуются рядом свойств, сближающих их с животными и растениями.
Общие признаки грибов и животных:
• В оболочке клеток есть хитин;
• в качестве запасного продукта у них накапливается гликоген, а не крахмал;
• в результате обмена образуется мочевина;
• отсутствие хлоропластов и фотосинтезирующих пигментов;
Общие признаки грибов и растений:
• Неограниченный рост;
• абсорбтивное питание, т.е. не заглатывание пищи, а всасывание;
• наличие ярко выраженной клеточной стенки;
• размножение спорами;
• неподвижность;
• способность синтезировать витамины.
Слайд 7Питание грибов
Грибы-сапрофиты питаются мертвыми органическими веществами, а паразиты могут обитать
на растениях, животных и человеке. Имеются также переходные формы грибов
(трутовики и др.), которые часть своей жизнедеятельности проводят как сапрофиты, а другую часть — как паразиты. Грибы-сапрофиты обитают на опавших листьях, древесине и перегное.
Многие виды царства Грибов живут в сожительстве (симбиозе) с водорослями и с высшими растениями. Взаимовыгодное сожительство мицелия грибов с корнями высших растений образует микоризу (например, подберезовик с березой, подосиновик с осиной).
Многие высшие растения (деревья, твердая пшеница и др.) не могут нормально расти без микоризы. Грибы получают от высших растений кислород, выделения корней и соединения, не содержащие азота. Грибы «помогают» высшим растениям усваивать труднодоступные вещества из перегноя, активизируя деятельность ферментов высших растений, способствуют углеводному обмену, фиксируют свободный азот, который в ряде соединений используется высшими растениями, дают им ростовые вещества, витамины и т.п.
Строение грибов
Царство Грибы условно подразделяют на низшие и высшие. Основа вегетативного тела грибов — грибница, или мицелий. Грибница состоит из тонких нитей, или гиф, похожих на пушок. Эти нити находятся внутри субстрата, на котором обитает гриб.
Чаще всего грибница занимает большую поверхность. Через мицелий происходит всасывание питательных веществ осмотическим путем. Грибница низших грибов либо разделяется на клетки, либо межклеточные перегородки отсутствуют.

Слайд 8Одно- или многоядерные клетки грибов в большинстве случаев покрыты тонкой
клеточной оболочкой. Под ней находится цитоплазматическая мембрана, окутывающая цитоплазму.
В клетке
грибов имеются ферменты, белки и такие органоиды (лизосомы), в которых протеолитическими ферментами расщепляются белки. Митохондрии имеют сходство с таковыми у высших растений. В вакуолях содержатся запасные питательные вещества: гликоген, липиды, жирные кислоты, жиры и др.
В съедобных грибах имеется много витаминов и минеральных солей. Примерно 50% сухой массы грибов составляют азотистые вещества, из которых на белки приходится около 30%.
Размножение грибов
Размножение грибов происходит бесполым путем:
• Специализированными клетками — спорами;
• вегетативно — частями мицелия, почкованием.
Процессу спорообразования может предшествовать половой процесс, который у грибов очень разнообразен. Зигота может образовываться в результате слияния соматических клеток, специализированных на гаметы, и половых клеток — гамет (образующихся в половых органах — гаметангиях). Образовавшаяся зигота прорастает сразу или после периода покоя и дает начало гифам с органами полового спороношения, в которых образуются споры.
Споры различных грибов распространяются насекомыми, различными животными, человеком и воздушными течениями.

Слайд 113. Структура грибной клетки
Грибы отличаются от всех эукариотов наиболее простым
строением клетки.
Обычно она состоит из оболочки, протопласта, вакуолей. В состав
протопласта входит цитоплазма и ядро. Цитоплазма содержит органоиды, находящиеся в гиалоплазме.
Клеточная оболочка. Ее свойства зависят от многих функций грибов, особенно тех, которые связаны с контактом грибной клетки с внешней средой. Состав клеточной оболочки изменяется при переходе из одной фазы роста в другую или зависит от типов роста — дрожжеподобный, гифальный и т. д.
Грибы отличаются разнообразным составом клеточной оболочки. Она может быть целлюлозно-хитиновой, хитиново-глюкановой. В ней имеются гетерополимеры, содержащие маннозу, глюкозу, галактозу. Один из основных компонентов клеточной оболочки — хитин (азотсодержащее, нерастворимое в крепких растворах щелочей вещество). Он составляет у некоторых грибов до 60% сухого веса оболочки. У грибов из отдела Zygomycota (мукоральные грибы) в клеточной оболочке обнаружен хитозан. Клеточная оболочка придает форму вегетативным клеткам гиф и органам размножения, ее поверхность является местом локализации некоторых ферментов. Она часто многослойна, устойчива к разрушению. По мере старения оболочка может кутинизироваться, инкрустироваться оксалатом кальция. Наружные слои оболочки могут ослизняться.

Слайд 12Протопласт. Это сферическое образование клетки, которому свойственны метаболические процессы и
способность к регенерации. От клеточной оболочки протопласт отделен плазмалеммой —
мембраной, содержащей липиды и белки. Главная ее функция — регуляция поступления растворов из окружающей среды в клетку и наоборот. Поступление веществ может быть пассивным и активным, протекающим с затратами энергии в виде АТФ. В протопласте различают ядро и цитоплазму. В состав цитоплазмы входят разнообразные органоиды (митохондрии, эндоплазматическая сеть, рибосомы и др.), связанные гиалоплазмой. В ней формируются надмолекулярные агрегаты — микрофиламенты и микротрубочки, обусловливающие цитоскелет клетки. У грибов большее значение имеют микрофиламенты, у растений — микротрубочки. Рибосомы находятся в основном в цитоплазме. Эндоплазматический ретикулюм выражен слабо. Митохондрии похожи на митохондрии растений, но кристы сплющенные или тарелкообразные. Диктиосомы (тельца Гольджи), имеющие большое значение у растений в формировании клеточной стенки, практически не встречаются. Вместо диктиосом обнаруживаются скопления эндоплазматического ретикулюма с небольшим количеством ламелл. Одной из особенностей протопласта клетки грибов является наличие около цитоплазматической мембраны губковидных электронно-прозрачных телец — ломасом, функции которых окончательно не выяснены.
Ядро. У большинства грибов оно обычно небольших размеров, окружено двойной мембраной, круглое, удлиненное, расположено либо в центре, либо у клеточной оболочки или перегородки. Клетки гиф содержат одно или несколько ядер. В ядре обычно находится одно ядрышко, но иногда оно отсутствует. Основная функция ядра — репликация ДНК и перенос генетической информации в цитоплазму через РНК. К особенностям ядерного аппарата грибов относится наличие дикарионов (n + n), спаренных ядер в клетке после слияния цитоплазмы. Другая особенность ядер — способность передвигаться из одной клетки в другую.

Слайд 13Следует отметить некоторые особенности митоза. У большинства грибов митоз «закрытый»
(без разрушения ядерной оболочки), отсутствуют центриоли. Образование перегородки между разделившимися
клетками не всегда происходит сразу после деления ядра, в результате чего могут образоваться многоядерные клетки.
Вакуоли. Отграничены от протопласта мембраной — тонопластом. В молодых клетках вакуоли мелкие. Впоследствии они сливаются, образуя крупную вакуоль. В вакуолях в коллоидном состоянии находятся полифосфаты, различные питательные вещества. У низкоорганизованных грибов и в зооспорах имеются особые пульсирующие вакуоли, способные сокращаться и вновь расширяться.
Жгутики имеются у представителей отдела хитридиомикота. Они способствуют передвижению зооспор и гамет. По строению отличаются от жгутиков бактерий, но похожи на жгутики простейших, гамет растений и многих животных. В центре находятся две одиночные, а по периферии — девять двойных фибрилл.
Слайд 154. Классификация грибов
Классы разграничиваются на основании типа органов размножения и
ряда признаков строения вегетативного тела грибов.
Царство грибов делится на два
отдела:
1. Оомикота.
К этому отделу принадлежат только два класса: оомицеты и гифохитриомицеты. Они отличаются числом жгутиков и составом клеточных оболочек.
2. Эумикота (настоящие грибы).
К данному отделу относится подавляющее большинство грибов (96%), в котором различают пять классов: хитридиомицеты, зигомицеты, аскомицеты, базидиомицеты, дейтеромицеты.
Общепринятой классификации грибов в настоящее время не существует, поэтому приведённые в литературе либо иных источниках сведения могут существенно различаться у разных авторов. За основу классификации берётся чаще всего способ размножения.
Хитридиомицеты (Chytridiomycota) — гаплоидный многоядерный синцитий (плазмодий), клеточная стенка отсутствует, вегетативное размножение не обнаружено, одножгутиковые зооспоры, полового спороношения нет, гаметы подвижны, изо- или гетерогамия, все представители паразиты.
Зигомицеты (Zygomycota) — гаплоидный синцитий (иногда с небольшим количеством перегородок), помимо хитина в клеточной стенке много пектина, способность к почкованию, бесполое размножение спорангиоспорами, зигогамия.

Слайд 16Аскомицеты (Ascomycota) или Сумчатые грибы — хорошо развитый многоклеточный гаплоидный
мицелий, способность к почкованию и образованию склероций, конидии, гаметангиогамия с
образованием сумок с аскоспорами. Аскомицеты представляют собой одну из самых многочисленных групп грибов — более 32000 видов (~30 % всех известных науке видов грибов). Их отличает огромное разнообразие — от микроскопических почкующихся форм до обладающих очень крупными плодовыми телами грибов.
Базидиомицеты (Basidiomycota) — многоклеточный, как правило дикариотический мицелий, могут образовывать хламидоспоры, соматогамия или автогамия с образованием базидий с базидиоспорами. Группа включает подавляющее большинство грибов, употребляемых человеком в пищу, а также ядовитых грибов и многих паразитов культурных и диких растений. Всего насчитывается свыше 30000 видов.
Дейтеромицеты (Deuteromycota) или несовершенные грибы (Anamorphic fungi) — в эту гетерогенную группу объединены все грибы с развитым мицелием, размножающиеся частями мицелия и конидиями и с неизвестным до настоящего времени половым процессом. Насчитывается около 30000 видов.
Грибы-паразиты.
Есть виды, вызывающие заболевания деревьев (трутовики), злаковых культур (головневые грибы), картофеля (фитофтора, переведена в царство протистов).
Другие приспособились к разнообразным условиям среды, являются редуцентами органических веществ и способствуют повышению плодородия почвы, а также используются человеком в пищу, служат сырьем для получения антибиотиков, органических кислот, ферментов.

Слайд 195. Роль грибов в природе и деятельности человека
В природе
Грибы играют
важную роль в круговороте веществ в природе. Они разлагают органические
вещества почвы до неорганических, которые далее усваиваются растениями. Почвенные грибы, в первую очередь плесневые, играют исключительную роль в процессах почвообразования. В грибах накапливаются органические вещества, которые после разрушения грибницы превращаются в перегной.
Микориза ( симбиотическая ассоциация мицелия гриба с корнями высших растений) положительно влияет на жизнедеятельность растений. Кроме шляпочных, микоризу образуют многие плесневые грибы. Они вступают во взаимовыгодные отношения преимущественно с травянистыми растениями, включая большинство культурных видов.
Плодовые тела шляпочных грибов потребляют в пищу многие животные: млекопитающие(белки, мышевидные грызуны, барсуки, кабаны, косули), наземные моллюски и особенно насекомые.
В хозяйственной деятельности человека
Известно свыше 100 видов съедобных грибов, но в пищу используют не более 40. Они богаты питательными веществами, однако их пищевая ценность сравнительно невелика. Это объясняется тем, что хитиновая стенка клеток грибов препятствует их перевариванию в кишечнике.

Слайд 20В медицине
Несколько видов съедобных грибов, например шампиньоны и вешенки, искусственно
выращивают в специальных помещениях. Из многих плесневых грибов (пеницилл, аспергилл
и др.) получают искусственные вещества – антибиотики. Они избирательно губительно действуют на клетки паразитических бактерий и грибов, не принося вреда клеткам хозяина. У определенных видов грибов выявлены вещества, угнетающие рост клеток злокачественных опухолей человека и домашних животных. В качестве лекарственных препаратов используют вытяжку из спорыньи.
В пищевой промышленности
В хлебопекарной промышленности используют дрожжи. Благодаря углекислому газу, выделяющемуся при брожении, тесто становится пористым («поднимается»), что повышает вкусовые качества хлебобулочных изделий. Дрожжи также применяются в производстве пива, спирта, винно-водочных изделий. Особые дрожжи необходимы для получения кефира и кумыса (сквашенное молоко кобылы). Некоторые плесневые грибы используют при изготовлении определенных сортов твердых сыров с острым вкусом и специфическим запахом ( например, «Рокфор» и «Каламбер»). Из некоторых плесневых грибов получают вещества, усиливающие рост растений. С их помощью, например, удалось увеличить размеры ягод безсеменных сортов винограда. Некоторые виды грибов, паразитирующих в теле насекомых-вредителей, используют для борьбы с ними.

Слайд 21Вред грибов
Много видов грибов вредят здоровью человека и домашних
животных. Ядовитые шляпочные грибы, среди которых в России наиболее опасны
бледная поганка, панцирный мухомор, некоторые виды шампиньонов, сыроежек вызывают смертельные отравления. Они особенно опасны тем, что первые признаки отравлений проявляются только через несколько часов и даже дней после употребления, когда помощь оказывать уже поздно. Поэтому можно собирать только те виды, которые вам хорошо известны как съедобные. Нельзя собирать старые грибы. Даже если известно, что они съедобные: со временем в них накапливаются ядовитые вещества.
Часто люди отравляются, употребляя в пищу продукты питания, покрытые плесенью. Многие виды плесневых грибов содержат яды и вещества, способствующие образованию злокачественных опухолей. При отравлении грибами следует немедленно обратиться к врачу.
Значительные убытки приносят грибы-разрушители (трутовики и плесневые грибы). Они повреждают деревянные части строений, мебели, древесину на складах. Известны случаи, когда эти грибы разрушали целые города. Определенные виды плесневых грибов разрушают шпалы, деревянные опоры мостов, книги в хранилищах, музейные экспонаты.
Мы уже вспоминали, что фитофтора, трутовики и мучнеросые грибы способны полностью уничтожать пораженные растения. В Украине среди заболеваний растений также широко распространены головня злаковых культур (вместо зерновок в колосках возникают полости, заполненные черными мелкими спорами), парша яблони и груши (плоды и листья покрываются черными пятнами) и множество других. Потребление изделий из зерна, пораженного спорыньей, вызывает тяжелое, часто смертельное заболевание крови человека. При этом наблюдаются и нарушения деятельности нервной системы: судороги, галлюцинации. Разнообразные плесневые и дрожжевые грибы вызывают тяжелые заболевания кожи (парша, стригущий лишай) у человека и животных.

Слайд 236. Интересные факты о плесени
Плесень – особенный вид грибов, которому
прекрасно удается совмещать в себе признаки и растений и животных;
она ест, дышит, и последние исследования японских ученых доказали, что у плесени имеются зачатки интеллекта.
Плесень появилась гораздо раньше человека, около 200 миллионов лет назад.
Самой ядовитой является плесень желтого цвета, поражая пищевые продукты, она вырабатывает сильнейший афлатоксин.
Плесень может быть причиной повышенной утомляемости, головных болей, дерматологических, легочных и даже онкологических заболеваний. Плесень не выводится из организма.
Некоторые виды плесени могут разрушать штукатурку, кирпич и даже бетон.
На Кавказе находится пещера, где была обнаружена флуоресцентная плесень. Причем флюоресценция настолько сильна, что с половины метра можно легко различить черты лица.
В 1771 году в Москве началась эпидемия чумы. Григорий Орлов, фаворит Екатерины, дал указание бить в набатные колокола, как это издавна повелось во время бед и напастей. И, как по чуду, эпидемия пошла на спад. Однако недавние исследования показали, что колокола просто обладают частотным спектром звучания, который угнетает рост патогенных микробов и плесени, и заодно повышает иммунитет человека.

Слайд 24После проникновения в гробницу фараона Тутанхамона 24 ноября 1922 года
от неизвестной болезни скончалась большая часть команды английских археологов, участвующих
в поисках мумии. И лишь в 1999 году немецкий микробиолог Готтард Крамер исследовал более 40 мумифицированных тел и обнаружил, что каждое из них покрыто слоем очень опасной плесени, концентрация которой и повлекла смерть вошедших в гробницу.
Плесень совсем не боится радиации. Например, под саркофагом 4-го энергоблока Чернобыльской АЭС находится огромное количество плесени. В местах усиленного радиационного фона она наиболее густая.
Споры плесневых грибов летали в космос на обшивке космического корабля. Время показало, что в безвоздушном пространстве она не только выжила, но и обзавелась сильным иммунитетом к возмущающим факторам. Некоторые даже называют плесень главной причиной отказа аппаратуры станции «Мир».
Помимо агрессивной и опасной плесени существует и та, которую можно употреблять в пищу. Во Франции ее используют для приготовления вин и называют «благородной». С помощью специально выращенной голубой плесени делают мраморные и голубые сыры.
Особый и очень дорогой деликатес – колбаса с плесенью, которую делают в Италии. Колбаску выдерживают в подвальных помещениях около месяца, после чего она покрывается светло-зеленой плесенью и отправляется на специальную обработку, и уже через три месяца ей можно полакомиться.

Слайд 28Спасибо за внимание!
Выполнили:
Конькова А.
Маслякова Т.
Одобецкая П.
Брызгалова А.
Ахметдинов Я.
Тихонова О.
Афанасьева А.
Кузнецова
Е.
Щурова П.
Прилепская Д.
Нефедов А.
Плюснин Д.
Смирнов Р.
Минязева А.
Хайрулина А.